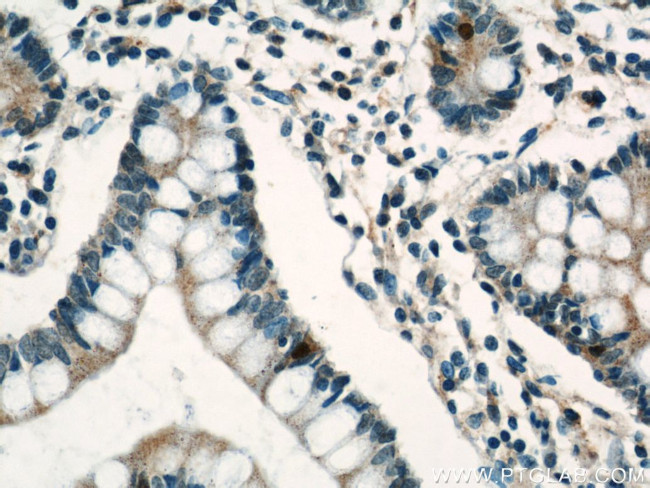
Lin28A Antibody in Immunohistochemistry (Paraffin) (IHC (P))

Search
Proteintech
Lin28A Polyclonal Antibody
{{$productOrderCtrl.translations['antibody.pdp.commerceCard.promotion.promotions']}}
{{$productOrderCtrl.translations['antibody.pdp.commerceCard.promotion.viewpromo']}}
{{$productOrderCtrl.translations['antibody.pdp.commerceCard.promotion.promocode']}}: {{promo.promoCode}} {{promo.promoTitle}} {{promo.promoDescription}}. {{$productOrderCtrl.translations['antibody.pdp.commerceCard.promotion.learnmore']}}
产品信息
16177-1-AP
种属反应
已发表种属
宿主/亚型
分类
类型
抗原
偶联物
形式
浓度
规格
纯化类型
保存液
内含物
保存条件
运输条件
产品详细信息
This antibody is a rabbit polyclonal antibody raised against a peptide mapping within human LIN28.This antibody recognize Lin28A specifically.
靶标信息
Lin28 is a transcription factor that was first identified through its key role in the pathway of developmental timing in C. elegans. The role of Lin28 in development suggested that it might be useful in the creation of stem cells that might be beneficial in cell replacement therapies in the treatment of several degenerative diseases. Artificial stem cells, termed induced pluripotent stem (iPS) cells, can be created by expressing Lin28 in addition to the transcription factors POU5F1, Sox2, and NANOG in mouse fibroblasts. More recently, experiments have demonstrated that iPS cells could be generated using expression plasmids expressing Lin28, Sox2, POU5F1 and c-Myc, eliminating the need for virus introduction, thereby addressing a safety concern for potential use of iPS cells in regenerative medicine.
仅用于科研。不用于诊断过程。未经明确授权不得转售。
生物信息学
蛋白别名: FLJ12457; Lin-28A; Protein lin-28 homolog A; RNA-binding protein LIN-28; testis expressed gene 17; Testis-expressed protein 17; unnamed protein product; Zinc finger CCHC domain-containing protein 1; zinc finger, CCHC domain containing 1
基因别名: AL024421; CSDD1; ENSMUSG00000070700; Gm10299; LIN-28; lin-28A; LIN28; LIN28A; RGD1566408; Tex17; ZCCHC1
UniProt ID: (Human) Q9H9Z2, (Mouse) Q8K3Y3
Entrez Gene ID: (Human) 79727, (Rat) 500562, (Mouse) 83557